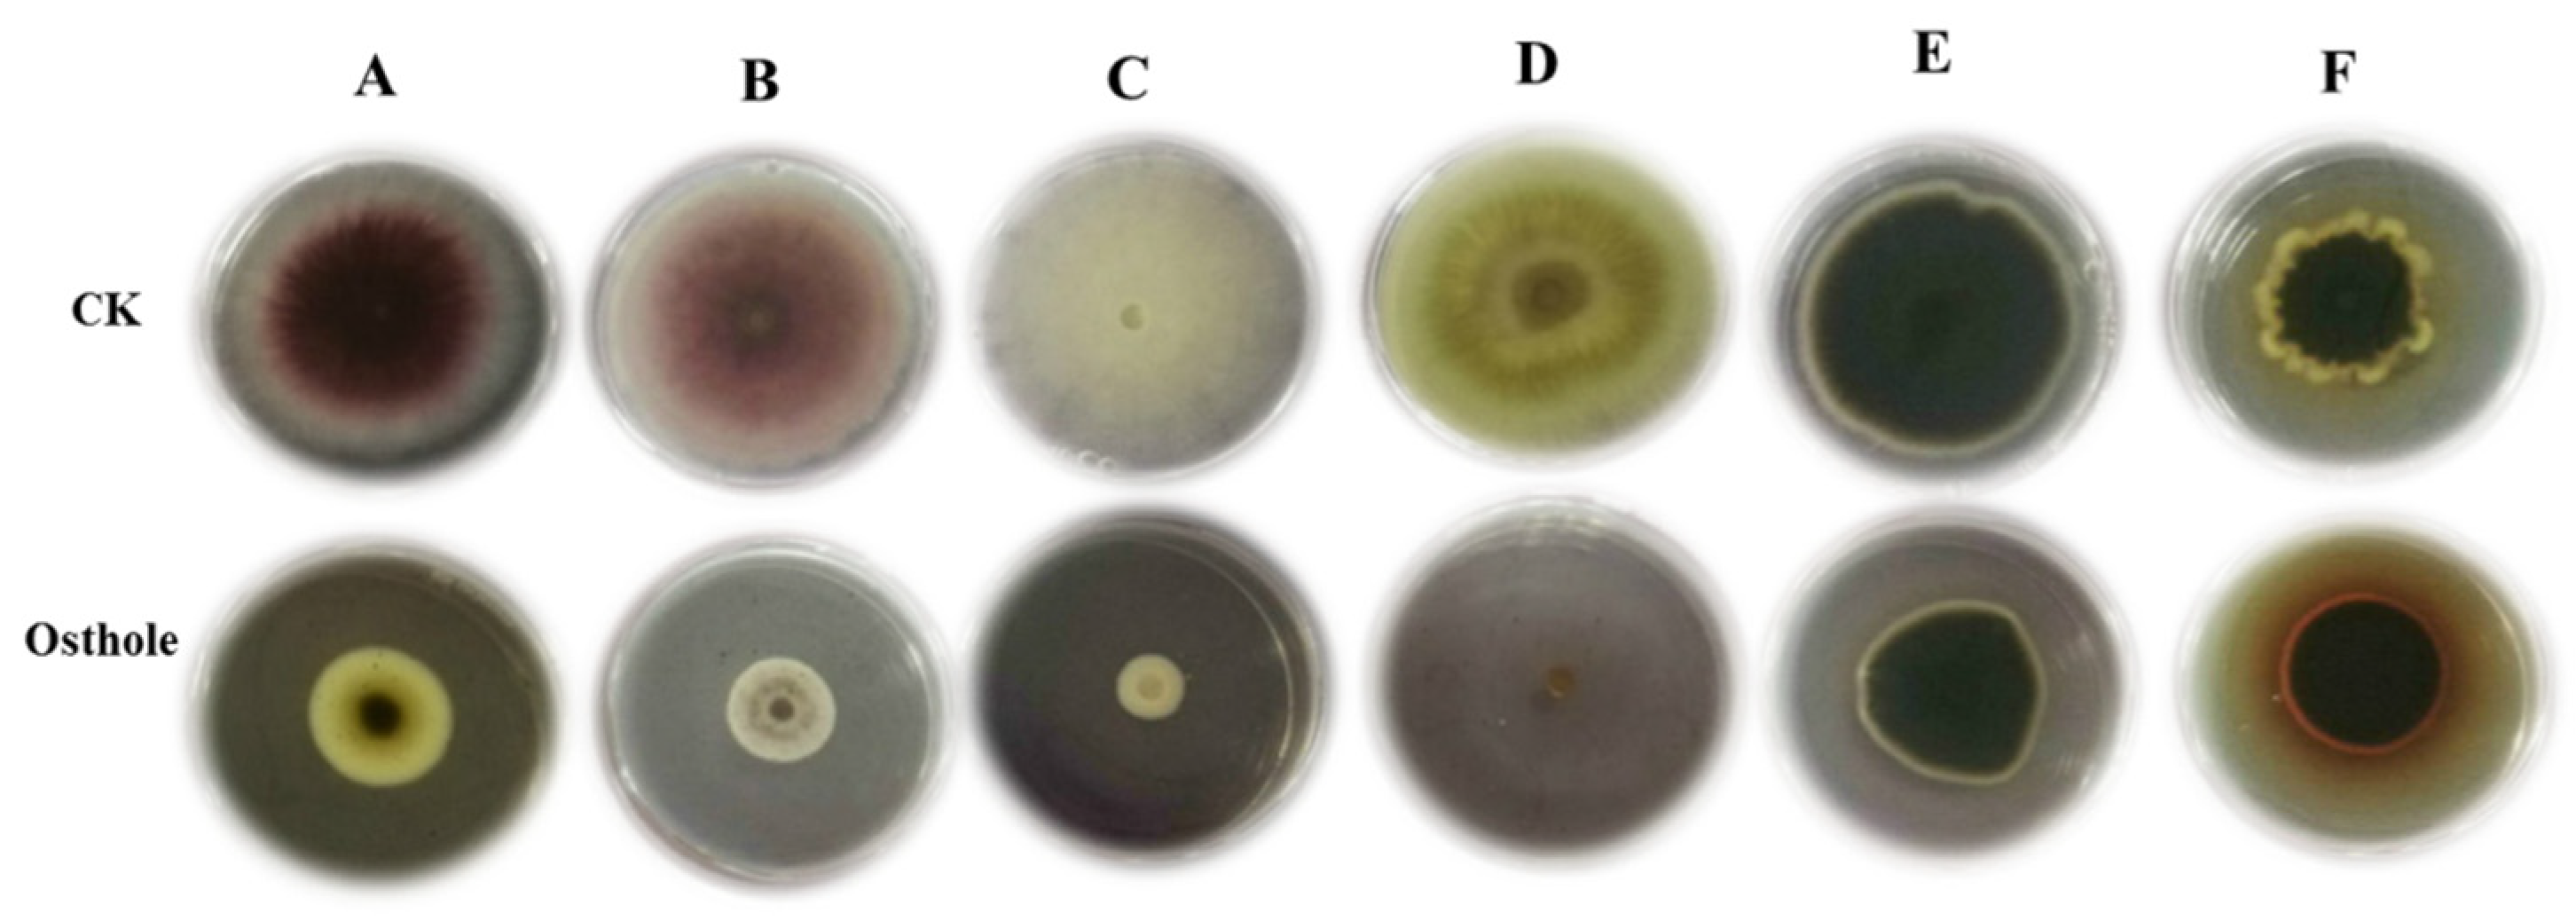
Molecules 26 03818 g004

Abstract
Fusarium wilt of potato is one of the most common diseases of potato in China, and is becoming a serious threat in potato production. It has been reported that osthole from Cnidium monnieri (L.) Cusson can inhibit plant pathogens. Here, we test the anti-fungal activity of C. monnieri osthole against Fusarium oxysporum in potatoes. The results showed that at a concentration of 5 mg/mL, osthole was able to obviously inhibit mycelial growth of F. oxysporum. We found that osthole caused changes of mycelial morphology, notably hyphal swelling and darkening. Osthole significantly reduced the spore germination of Fusarium by 57.40%. In addition, osthole also inhibited the growth of other pathogens such as Fusarium moniliforme J. Sheld, Thanatephorus cucumeris Donk, and Alternaria alternata (Fr.) Keissl, but not Alternaria solani Jonesetgrout and Valsa mali Miyabe and G. Yamada. Our results suggest that osthole has considerable potential as an agent for the prevention and treatment of potato Fusarium wilt.
1. Introduction
Potato Fusarium wilt is a typical soil-borne disease that leads to severe wilt symptoms, ultimately resulting in plant death, which directly affects the yield and quality of potatoes [1,2,3]. This disease is widely distributed worldwide and generally causes about 30% reduction in production. According to the reports of Rakhimov et al. (2000), potato Fusarium wilt is mainly caused by either of five different Fusarium varieties, i.e., Fusarium oxysporum Schlecht, F. solani (Mart.) Sacc., F. moniliforme Sheld, F. sambucinum Fuckel, and F. nivale (Fr.) Ces. F. oxysporum Schlecht, F. solani (Mart.) Sacc., and F. nivale (Fr.) Ces are the agents of potato Fusarium wilt in Inner Mongolia, China.
Because the disease is a soil-borne disease and the pathogen exhibits a strong resistance to stress, it is difficult to treat soil with chemicals in the field [4]. At present, the control of potato Fusarium wilt mainly relies on agricultural and chemical seed dressing methods. Environmental pollution and the persistence of fungicide residues in potato tubers are important concerns in the control of potato Fusarium wilt. Thus, plant-derived fungicides are promising alternatives because they are largely non-phytotoxic, easily biodegradable, and environmentally safe [5]. Plant compounds with antifungal properties include proteins, alkaloids, flavonoids, phenols, essential oils, and polysaccharides [5,6,7,8,9,10]. Cnidium monnieri (L.) Cusson is a traditional Chinese medicinal plant widely distributed throughout China [11,12,13]. A total of 429 chemical compounds have been detected in C. monnieri, and of these 56 have been chemically identified [14]. Osthole is an O-methylated coumarin isolated and purified from the seeds of C. monnieri. It was widely shown to have pharmacological functions, such as anti-allergic, anti-pruritic, anti-bacterial, anti-dermatophytic, anti-osteoporotic, and anti-fungal activities in humans [15,16,17,18,19]. Furthermore, osthole was found to enhance osteogenesis in osteoblasts by elevating transcription factor osterix via cyclic adenosine monophosphate (cAMP)/the cAMP response element-binding protein (CREB) signaling [20].
However, its anti-fungal activity against plant pathogens remains unknown. Previously, we identified the osthole from C. monnieri and found that osthole inhibited the infection of Nicotiana glutinosa by the Tobacco mosaic virus (TMV) [21]. This led us to wonder whether osthole could inhibit the pathogen of potato Fusarium wilt. In this study, we investigated the effects of osthole on mycelium growth and spore production of Fusarium oxysporum Schlecht. The activity of osthole against other fungal pathogens was also tested with the aim of exploring possible applications of osthole in the control of plant fungal diseases.
2. Results
2.1. Osthole Effects on the Growth of F. oxysporum
The effect of osthole on F. oxysporum was examined on potato dextrose agar (PDA) plates containing 5 mg/mL osthole. Compared with the control (water), the mycelial growth was significantly inhibited in plates containing osthole, as evidenced by mycelial growth inhibition at 3 days after inoculation (Figure 1A). The mycelial growth inhibition was 55.34%, a value that was comparable to that observed with three other compounds of common use as fungal inhibitors, carbendazol wettable powder (82.49%), hymexazol aqueous solution (59.89%), and azoxystrobin (49.91%) (Figure 1B). This indicates that osthole is able to efficiently inhibit the mycelial growth of Fusarium oxysporum.
Figure 1.
The inhibitory effect of osthole on Fusarium oxysporum at 3 days after inoculation. (A) CK, potato dextrose agar (PDA) medium; (B) PDA medium plus 5 mg/mL osthole; (C) PDA medium plus 5 mg/mL carbendazol wettable powder; (D) PDA medium plus 5 mg/mL hymexazol aqueous solution; (E) PDA medium plus 5 mg/mL azoxystrobin; (F) The mycelial growth inhibition are shown. CK, PDA medium. The bars on the columns indicate standard deviation.
2.2. The Dose-Dependent Inhibitory Activity of Osthole on the Growth of F. oxysporum
To determine the optimal concentration of osthole for inhibiting mycelial growth, we diluted osthole in PDA medium (resulting in solutions of various concentrations) and inoculated the F. oxysporum mycelia. We found that the mycelial growth was considerably reduced when the concentration of osthole was increased to 1 mg/mL (Figure 2A,B). The mycelial growth inhibition in plates containing 0.005 mg/mL (6.55%) and 0.1 mg/mL (9.51%) osthole were no significant difference to those in the control. When the concentration of osthole reached 1 mg/mL, themycelial growth inhibition sharply increase ed to 33.83%. The inhibitory effect of osthole on the growth of F. oxysporum mycelia was more prominent at concentrations of 3 mg/mL or more (5 mg/mL and 7 mg/mL). Moreover, the mycelia morphology also exhibited pronounced malformations.
Figure 2.
The inhibitory effect of osthole at different concentrations on F. oxysporum. The colony morphology (A) and the mycelial growth inhibition (B) of F. oxysporum in media containing osthole, 5 days after inoculation.
Thus, a significant positive correlation was observed between the concentration of osthole and its inhibitory effects on the growth of F. oxysporum mycelia.
2.3. Effects of Osthole on Mycelia Morphology and Spore Germination of F. oxysporum
Mycelia morphology and spore germination of F. oxysporum were observed by optical microscopy and scanning electron microscopy (SEM). We found that osthole (5 mg/mL) induced morphological changes in F. oxysporum, characterized by shrunken hyphae with abnormal shape, vesicles, distortion, or empty cells devoid of cytoplasm in the mycelia (Figure 3B,D). Osthole induced a visible increase in mycelial branching, enlargement of apical branches, and malformation in F. oxysporum. No swelling or distortion was observed in the untreated controls (Figure 3A,C). Osthole also significantly inhibited the germination of F. oxysporum spores (Figure 3E,F). After incubation at 30 °C for 18 h, the germination of F. oxysporum spores was 14.45% in PDA medium containing 5 mg/mL osthole, versus 33.92% in the control (Table 1). This suggests that osthole affects mycelial growth and spore germination.
Figure 3.
Effect of osthole on the morphology of F. oxysporum mycelia and spore germination. (A): CK, images of Fusarium oxysporum mycelia on PDA medium acquired using optical microscope; (B): images of Fusarium oxysporum mycelia on PDA medium plus 5 mg/mL osthole acquired using optical microscope. Mycelial morphology was observed by scanning electron microscopy and is shown in (C) (CK) and (D) (5 mg/mL osthole). (E): CK, Spore germination of Fusarium oxysporum on PDA liquid medium; (F): Spore germination of Fusarium oxysporum on PDA liquid medium plus 3 mg/mL osthole.
Table 1.
Germination of F. oxysporum spores.
2.4. Inhibitory Activity of Osthole against Other Fungal Pathogens
In order to extend the possibility of osthole application in the control of other fungal diseases in plant, the inhibitory activity of osthole was tested against six fungal pathogens using the plate confrontation test. Osthole (5 mg/mL) could effectively inhibit the growth of F. oxysporum Schlecht, F. moniliforme Sheld, Thanatephorus cucumeris Donk, and F. Valsa mali Miyabeet Yamada, but not of A. alternata Keissler and Alternaria solani Jonesetgrout (Figure 4). The inhibition rate of F. oxysporum Schlecht, F. moniliforme Sheld, T. cucumeris Donk, and V. mali Miyabeet Yamada were 55.34%, 70.66%, 75.90%, and 90.36%, respectively, whereas no significant inhibitory activity was observed against A. alternata Keissler (37.60%) and A. solani Jonesetgrout (37.05%) (Table 2).
Figure 4.
Inhibitory effect of osthole on several fungal pathogens. (A) F. oxysporum Schlecht; (B) F. moniliforme Sheld); (C) T. cucumeris Donk; (D) V. mali Miyabeet Yamada); (E) A. solani Jonesetgrout; (F) A. alternata Keissler. PDA containing osthole (5 mg/mL) was used. CK, PDA dishes were added with the same volume of Tween-20 and distilled water (1:1000 v/v).
Table 2.
Mycelial diameter of six pathogens in response to osthole treatment in vitro.
3. Materials and Methods
3.1. Test Fungal Pathogens and Storage
F. oxysporum Schlecht, F. moniliforme Sheld, T. cucumeris Donk, V. mali Miyabeet Yamada, A. alternata Keissler, and A. solani Jonesetgrout were provided by the Microbiology Institute of Shaanxi, Shaanxi Province, China. V. mali Miyabe and G. Yamada was provided by the State Key Laboratory of Crop Stress Biology for Arid Areas, Northwest A and F University, Yangling, Shanxi, China. F. oxysporum Schlecht was obtained from the Laboratory of Phytopathology, Inner Mongolia Agricultural University, Huhhot Inner Mongolia, China. The fungi were stored at 4 °C on PDA (200 g potato peelings, 20 g dextrose, 15 g agar, and 1000 mL distilled water, pH 7.0) and grown in culture medium at 25 °C.
3.2. Chemicals and Materials
The osthole was extracted from C. monnieri (100 g) with 500 mL 90% methanol as described by Chen et al. 2019 [21].
Carbendazol WP (50%) was obtained from Jiangsu Sanshan Pesticide Co., Ltd. (Jiangsu, China). Hymexazol aqueous (30%) was purchased from Heyi chemical Co. LTD (Jiangxi, China). Azoxystrobin (25%) was purchased from Yinuo biochemical Co. LTD (Hebei, China). We chose these chemicals because they are effective antifungal reagents commonly used in controlling F. oxysporum in potato in China [22,23].
3.3. Inhibitory Activity of Osthole on the Growth of F. oxysporum Schlecht
We tested the effects of osthole on the growth of F. oxysporum Schlecht mycelia in PDA medium cultures using the agar dilution method [5]; control PDA plates without osthole were inoculated with equivalent fungi. First, osthole was dissolved in Dimethyl sulfoxide (DMSO) (1000 mg/mL) and diluted to required concentration with Tween-20 and distilled water (1:1000 v/v). We prepared the PDA plate containing 5 mg/mL of osthole. As the control, PDA dishes were added with the same volume of Tween-20 and distilled water (1:1000 v/v). The F. oxysporum Schlecht was inoculated on center of the plate. Three days later, the diameters of colonies were measured and the growth inhibition rates were calculated [5].
A series dilutions of osthole (0.005, 0.01, 0.10, 1.00, 3.00, 5.00, and 7.00 mg/mL) was prepared as described by Chen et al. in 2019 [5]. A 6 mm diameter disc of F. oxysporum Schlecht was inoculated at the center of the PDA plate. After incubation for 7 days at 25 ± 2 °C, the diameter of the inhibition zone was measured. Twelve plates of each group were tested. Each treatment was performed three times. We used the formula proposed by Chen et al. in 2019 to calculate mycelial growth inhibition [5].
3.4. Mycelia Observation by Scanning Electron Microscopy (SEM)
F. oxysporum Schlecht growing on PDA containing osthole (5 mg/mL) for 7 days were observed by SEM and their morphology was compared with that of the controls. Samples were prepared using the protocol proposed by Chen et al. (2019). All mycelia samples were observed using a Nova NanoSEM 450 (FEI Co. LTD, Hillsboro, OR, USA) at 5.00 kV of magnification.
3.5. Effects of Osthole on the Germination of F. oxysporum Schlecht Spores
Pathogen spore suspension at a concentration of ~40 spore/view (low-power scan; 10 × 10) and osthole at the 5 mg/mL concentration were mixed in equal volumes. One droplet was placed on a microscope slide coated with sterile collodion. Each treatment was repeated three times. The spores were considered as germinated when the length of germ tube exceeded the spore radius [24,25].
3.6. Statistical Analysis
All data are presented as mean values plus/minus SD from three independent replicates. The data were analyzed using a Data Processing System 15.10 (Hefei, China). The significance of the differences between the four means was determined using Duncan’s new complex range method at the 5% level.
4. Discussion
Osthole is a natural coumarin present in the fruits of Cnidium monnieri (L.) Cusson [26]. Crude extracts from the dried fruits of C. monnieri have been extensively used as a traditional Chinese medicine to treat various conditions such as osteoporosis [27], pulmonary inflammation [28] and certain skin diseases [15,18]. Thus, osthole is an important constituent of the dried fruits and has been recognized as a promising compound in drug discovery research. In particular, we previously identified the osthole from C. monnieri and and reported an obvious inhibition effect on TMV infection [21]. This stimulated us to test whether osthole could have antifungal activity in plant diseases, especially those soil-borne diseases.
In this study, we have chosen F. oxysporum Schlecht to test the antifungal effect of osthole. The results showed that at a concentration of 1 mg/mL, osthole was able to inhibit mycelial growth of F. oxysporum according to the increased growth inhibition. With the concentration increasing from 1 mg/mL to 7 mg/mL, no obvious difference of inhibition effect was observed. Based on this, 5 mg/mL of osthole was used for most assays. The changes of mycelia morphology also support an antifungal effect of osthole. We also performed the assay to explore the possibility whether osthole could affect the spore germination of Fusarium. The inhibition rate of 57.40% was obtained. These results are consistent with former reports of morphological alterations of fungal hyphae after treatment with chemical fungicides, chitosan, and natural botanicals [22,29,30,31]. These data greatly strengthen the possibility of utilizing osthole as plant-derived reagents in antifungal control in potato fusarium disease.
To further practical application points, we also explored the inhibition effect of osthole on other fungal pathogens in PDA plates. The results showed that osthole also inhibited the growth of other pathogens such as Fusarium moniliforme J. Sheld, Thanatephorus cucumeris Donk, and Alternaria alternata (Fr.) Keissl, but not the growth of Alternaria solani Jonesetgrout and Valsa mali Miyabe and G. Yamada. This suggested that osthole has a potential application in the prevention and treatment of some plant fungal diseases, but not all.
In conclusion, even though we found osthole could potentially be used as an inhibitory agent against plant fungal pathogens, its antifungal mechanism and crucial application points should be further studied before it can be used reliably.
Author Contributions
M.Z., Y.C. and H.Z. (Hongyou Zhou) designed the experiment. Y.C., J.Y. and Q.G. tested effects of osthole on mycelia growth; J.Y., H.W. and H.Z. (Hongli Zheng) analyzed effects of osthole on spore germination. H.Z. (Hongyou Zhou) and Y.C. observed the mycelium morphology. Q.G. performed the assay to check the antifungal activity of osthole against another five fungal pathogens. M.Z., Y.C. and H.Z. (Hongli Zheng) designed the experiments and supervised the study. M.Z., Y.C. and H.Z. (Hongli Zheng) wrote the manuscript. All authors have read and agreed to the published version of the manuscript.
Funding
This study was supported by Start-up Funding of High-level Talent Researcher in Inner Mongolia Agricultural University (No. NDGCC2016-23), Special Project for Transformation of Scientific and Technological Achievements of Inner Mongolia (2019CG026) and Science and Technology Project of Inner Mongolia (2019GG180).
Institutional Review Board Statement
The study did not applicable.
Informed Consent Statement
The study did not applicable.
Data Availability Statement
The study did not applicable.
Acknowledgments
We thank the Instrument Shared Platform of Northwest A and F University, the People’s Republic of China, for the liquid chromatography–mass spectrometry (LC-MS) and nuclear magnetic resonance (NMR).
Conflicts of Interest
The authors have no conflict of interest to declare.
Sample Availability
Samples of the compounds are not available from the authors.
References
- Rakhimov, U.K.; Khakimov, A.K. Wilt of potatoes in Uzbekistan. Zashchita I Karantin Rastenii 2000, 3, 46. [Google Scholar]
- Peng, X.W.; Zhu, J.H. Species and Distribution of potato Fungal Diseases in Hebei Province, China. Chin. Potato J. 2008, 22, 31–33. [Google Scholar]
- An, X.M.; Hu, J.; Wu, J.H.; Liu, Z.H.; Meng, M.L. Overview of pathogen causing potato Fusarium Wilt. Chin. Potato J. 2017, 31, 302–306. [Google Scholar]
- Khedher, S.B.; Mejdoub-Trabelsi, B.; Tounsi, S. Biological potential of Bacillus subtilis V26 for the control of Fusarium wilt and tuber dry rot on potato caused by Fusarium species and the promotion of plant growth. Biol. Control 2020, 152, 104444. [Google Scholar] [CrossRef]
- Chen, Y.H.; Lu, M.H.; Guo, D.S.; Zhai, Y.Y.; Miao, D.; Yue, J.Y.; Yuan, C.H.; Zhao, M.M.; An, D.R. Antifungal Effect of Magnolol and Honokiol from Magnolia officinalis on Alternaria alternata Causing Tobacco Brown Spot. Molecules 2019, 24, 2140. [Google Scholar] [CrossRef] [Green Version]
- Mi, Y.Y.; Byeong, J.C.; Jin, C.K. Recent Trends in Studies on Botanical Fungicides in Agriculture. Plant Pathol. 2013, 29, 1–9. [Google Scholar]
- Kijjoa, A.; Pinto, M.M.M.; Tantisewie, B.; Herz, W. A biphenyl type neolignan and biphenyl ether from Magnolia henryi. Phytochemistry 1989, 28, 1284–1286. [Google Scholar] [CrossRef]
- Du, C.M.; Wu, Y.H.; Zhao, X.X.; Zhu, C.Y.; Jiang, G.; Yan, X.M. Recent development in research of natural antiphytoviral substances. Acta Tabacaria Sin. 2004, 10, 34–40. [Google Scholar]
- Chen, Y.H.; Ru, B.L.; Zhai, Y.Y.; Li, J.; Cheng, J.L. Screening and inhibitory effects of plant extracts against Tobacco mosaic virus (TMV). J. Plant Prot. 2018, 45, 463–469. [Google Scholar]
- Zhao, L.; Feng, C.; Wu, K.; Chen, W.B.; Chen, Y.J.; Hao, X.A.; Wu, Y.F. Advances and prospects in biogenic substances against plant virus: A review. Pestic. Biochem. Phys. 2016, 135, 15–26. [Google Scholar] [CrossRef]
- Kitajima, J.; Aoki, Y.; Ishikawa, T.; Tanaka, Y. Monoterpenoid glucosides of Cnidium monnieri fruit. Chem. Pharm. Bull. 1999, 47, 639–642. [Google Scholar] [CrossRef] [Green Version]
- Oh, H.; Kim, J.S.; Song, E.K.; Cho, H.; Kim, D.H.; Park, S.E.; Lee, H.S.; Kim, Y.C. Sesquiterpenes with hepatoprotective activity from Cnidium monnieri on tacrine-induced cytotoxicity in Hep G2 cells. Planta Med. 2002, 68, 748–749. [Google Scholar] [CrossRef] [PubMed]
- Zhao, J.Y.; Zhou, M.; Liu, Y.; Zhang, G.L.; Luo, Y.G. Chromones and coumarins from the dried fructus of Cnidium monnieri. Fitoterapia 2011, 82, 767–771. [Google Scholar] [CrossRef] [PubMed]
- Sun, Y.; Yang, A.; Lenon, G.B. Phytochemistry, Ethnopharmacology, Pharmacokinetics and Toxicology of Cnidium monnieri (L.) Cusson. Int. J. Mol. Sci. 2020, 21, 1006. [Google Scholar] [CrossRef] [PubMed] [Green Version]
- Basnet, P.; Yasuda, I.; Kumagai, N.; Tohda, C.; Nojima, H.; Kuraishi, Y.; Komatsu, K. Inhibition of itch-scratch response by fruits of Cnidium monnieri in mice. Biol. Pharm. Bull. 2001, 24, 1012–1015. [Google Scholar] [CrossRef] [PubMed] [Green Version]
- Bao, J.J.; Xie, M.L.; Zhu, L.J. Treatment of osthol on osteoporosis in ovariectomized rats. Chin. Pharm. Bull. 2011, 27, 591–592. [Google Scholar]
- Matsuda, H.; Ido, Y.; Hirata, A.; Ino, Y.; Naruto, S.; Amamiya, T.; Kubo, M. Antipruritic effect of Cnidii monnieri Fructus (fruits of Cnidium monnieri Cusson). Biol. Pharm. Bull. 2002, 25, 260–263. [Google Scholar] [CrossRef] [PubMed] [Green Version]
- Matsuda, H.; Tomohiro, N.; Ido, Y.; Kubo, M. Anti-allergic effects of Cnidii monnieri fructus (dried fruits of Cnidium monnieri) and its major component, osthol. Biol. Pharm. Bull. 2002, 25, 809–812. [Google Scholar] [CrossRef] [Green Version]
- Li, Y.M.; Jia, M.; Li, H.Q.; Zhang, N.D.; Wen, X.; Rahman, K.; Zhang, Q.Y.; Qin, L.P. Cnidium monnieri: A Review of Traditional Uses, Phytochemical and Ethnopharmacological Properties. Am. J. Chin. Med. 2015, 43, 835–877. [Google Scholar] [CrossRef]
- Zhang, Z.R.; Leung, W.N.; Li, G.; Kong, S.K.; Lu, X.; Wong, Y.M.; Chan, C.W. Osthole Enhances Osteogenesis in Osteoblasts by Elevating Transcription Factor Osterix via cAMP/CREB Signaling In Vitro and In Vivo. Nutrients 2017, 9, 588. [Google Scholar] [CrossRef] [Green Version]
- Chen, Y.H.; Guo, D.S.; Lu, M.H.; Yue, J.Y.; Liu, Y.; Shang, C.M.; An, D.R.; Zhao, M.M. Inhibitory Effect of Osthole from Cnidium monnieri on Tobacco Mosaic Virus (TMV) Infection in Nicotiana glutinosa. Molecules 2019, 25, 65. [Google Scholar] [CrossRef] [Green Version]
- Chen, C.; Chen, Y.; Wang, C.; Wang, C.; Zhang, S.; Zhang, F. Fungicide selection in controlling potato blight. Guizhou Agric. Sci. 2014, 42, 43–45. [Google Scholar]
- Xue, Y.; Meng, M.; Hu, J.; Zhang, X.; Wang, X. Determination for Toxicity of Six Fungicides to Fusarium Wilt Pathogen of Potato in vitro. Chin. Potato J. 2012, 26, 228–230. [Google Scholar]
- Sun, P.P.; Jia, X.H.; Cui, J.C.; Tong, W.; Wang, W.H. Selection, Identification and Characterization of Actinomyces L-30 for theBiocontrol of Pear Gray Mold. Acta Hortic. Sin. 2016, 43, 2335–2346. [Google Scholar]
- Shan, H.Y.; Zhao, M.M.; Chen, D.X.; Chen, J.L.; Li, J.; Feng, Z.Z.; Ma, Z.Y.; An, D.R. Biocontrol of rice blast by the phenaminomethylacetic acid producer of Bacillus methylotrophicus strain BC79. Crop Prot. 2013, 44, 29–37. [Google Scholar] [CrossRef]
- Callahan, B.N.; Kammala, A.K.; Syed, M.; Yang, C.; Occhiuto, C.J.; Nellutla, R.; Chumanevich, A.P.; Oskeritzian, C.A.; Das, R.; Subramanian, H. Osthole, a Natural Plant Derivative Inhibits MRGPRX2 Induced Mast Cell Responses. Front. Immunol. 2020, 11, 703. [Google Scholar] [CrossRef] [PubMed]
- Zhang, Q.; Qin, L.; He, W.; Van Puyvelde, L.; Maes, D.; Adams, A.; Zheng, H.; De Kimpe, N. Coumarins from Cnidium monnieri and their antiosteoporotic activity. Planta Medica 2007, 73, 13–19. [Google Scholar] [CrossRef] [Green Version]
- Kwak, H.G.; Lim, H.B. Inhibitory effects of Cnidium monnieri fruit extract on pulmonary inflammation in mice induced by cigarette smoke condensate and lipopolysaccharide. Chin. J. Nat. Med. 2014, 12, 641–647. [Google Scholar] [CrossRef]
- Jing, C.L.; Zhao, J.; Han, X.B.; Huang, R.H.; Cai, D.S.; Zhang, C.S. Essential oil of Syringa oblata Lindl. as a potential biocontrol agent against tobacco brown spot caused by Alternaria alternata. Crop Prot. 2018, 104, 41–46. [Google Scholar] [CrossRef]
- Bajpai, V.K.; Sharma, A.; Baek, K.H. Antibacterial mode of action of Cudrania tricuspidata fruit essential oil, affecting membrane permeability and surface characteristics of food-borne pathogens. Food Control 2013, 32, 582–590. [Google Scholar] [CrossRef]
- Zhou, H.; Tao, N.; Jia, L. Antifungal activity of citral, octanal and α-terpineol against Geotrichum citri-aurantii. Food Control 2014, 37, 277–283. [Google Scholar] [CrossRef]
Publisher’s Note: MDPI stays neutral with regard to jurisdictional claims in published maps and institutional affiliations. |
© 2021 by the authors. Licensee MDPI, Basel, Switzerland. This article is an open access article distributed under the terms and conditions of the Creative Commons Attribution (CC BY) license (https://creativecommons.org/licenses/by/4.0/).